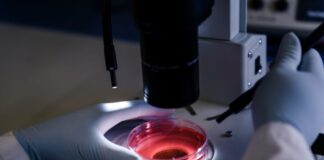
Casos diagnosticados de leucemia no Brasil disparam em 10 anos

Tag: saúde
Governo zera imposto de importação de insumos para canetas emagrecedoras da...
A iniciativa faz parte de um pacote federal que eliminou tarifas sobre quase mil itens diante da baixa oferta ou ausência de produção no...
Saúde libera R$ 900 mil para combate ao Chikungunya em Dourados
Valor será transferido em parcela única
Brasília – O Ministério da Saúde liberou aporte emergencial de R$ 900 mil para ações de vigilância, assistência e...
Vacinação contra gripe começa sábado em meio à alta de casos...
Doses já começaram a ser distribuídas, e campanha prioriza grupos mais vulneráveis; imunização anual é a principal forma de evitar casos graves, internações e...
Anvisa determina apreensão de azeite de oliva extravirgem
Agência reguladora fiz que produto tem origem desconhecida
Brasília – A Agência Nacional de Vigilância Sanitária (Anvisa) determinou nesta segunda-feira (16) a apreensão do azeite...
Entenda a síndrome que está levando crianças e adolescentes a internações...
Burnout digital não é apenas cansaço excessivo após um dia com o celular na mão. Este é o nome da síndrome que tem levado...
Butantan antecipa entrega de 1,3 mi de vacinas contra dengue ao...
Serão distribuídas 2,6 milhões de doses no primeiro semestre
Brasil – O Instituto Butantan anunciou nesta terça-feira (24) que antecipará para o primeiro semestre de...
Casos diagnosticados de leucemia no Brasil disparam em 10 anos
Hematologista atribui o crescimento ao envelhecimento acelerado da população e à melhoria do diagnóstico da doença
Brasília – A Estimativa 2026 – Incidência de Câncer...
Primeira morte por chikungunya no Brasil em 2026 é registrada em...
Estado também investiga outra morte suspeita
Mato Grosso – O Estado do Mato Grosso confirmou a primeira morte por chikungunya no Brasil em 2026, registrada...
MP apurar uso irregular de canetas emagrecedoras em Manaus
Iniciativa busca investigar a comercialização, manipulação e aplicação dos medicamentos
Manaus – Diante de indícios de comercialização e uso irregular de medicamentos utilizados para emagrecimento,...
Saúde alerta sobre cuidados com animais peçonhentos em Manaus
Foram registradas 398 notificações de acidentes por animais peçonhentos na capital, envolvendo principalmente serpentes, aranhas e escorpiões
Manaus – Manaus registrou 398 notificações de acidentes...